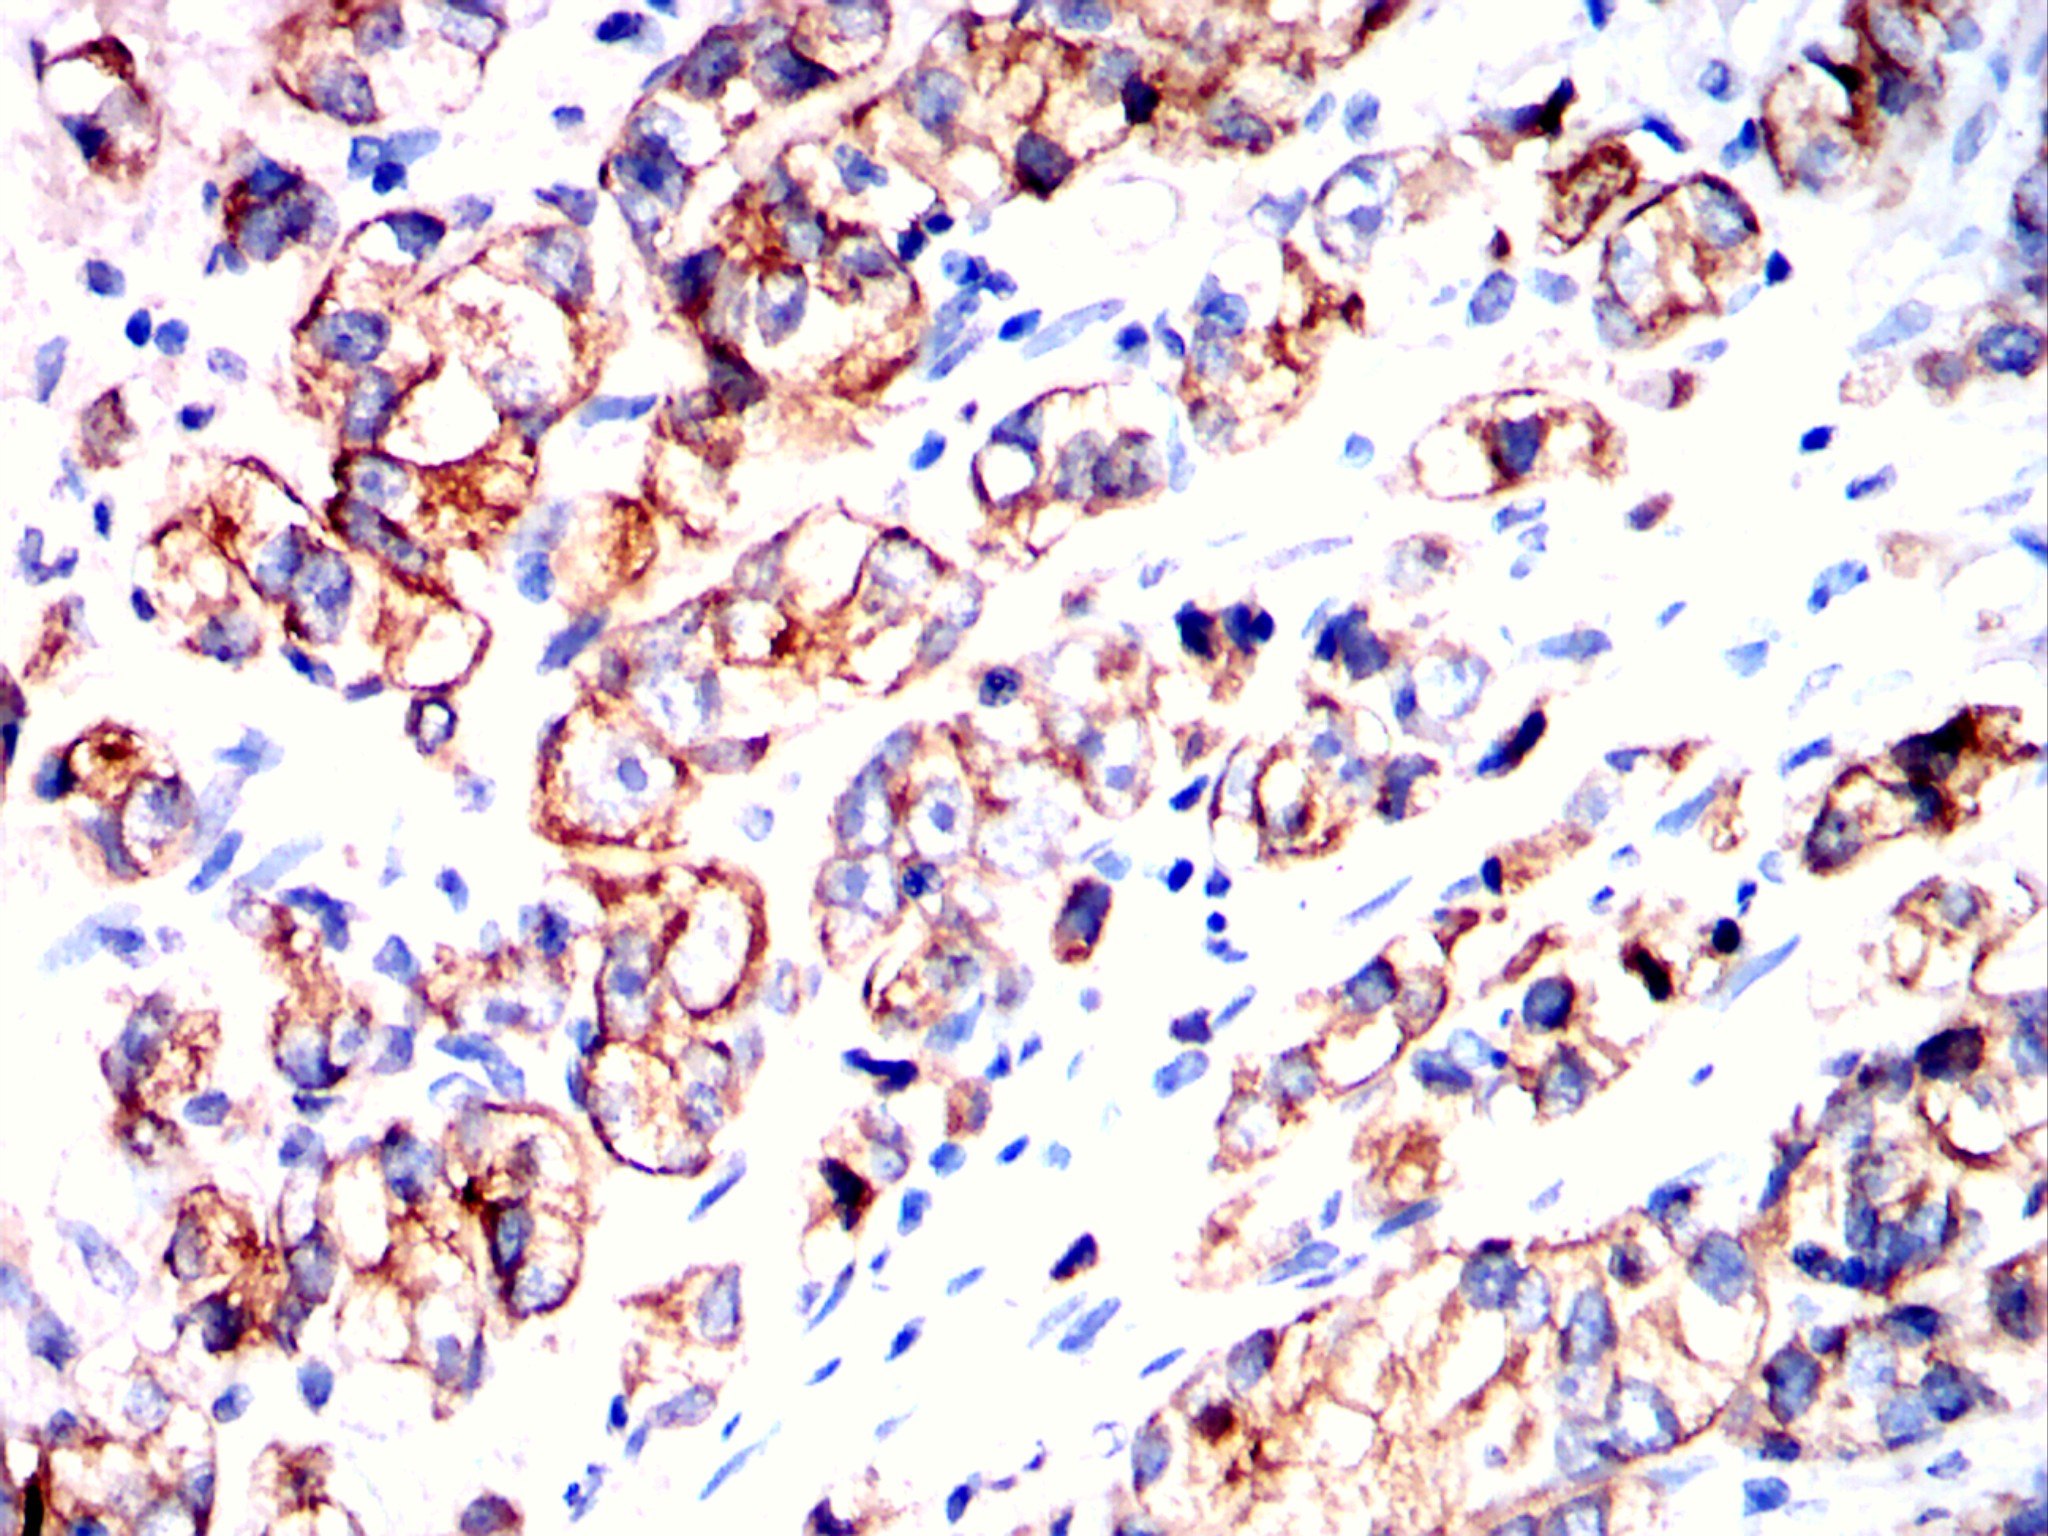
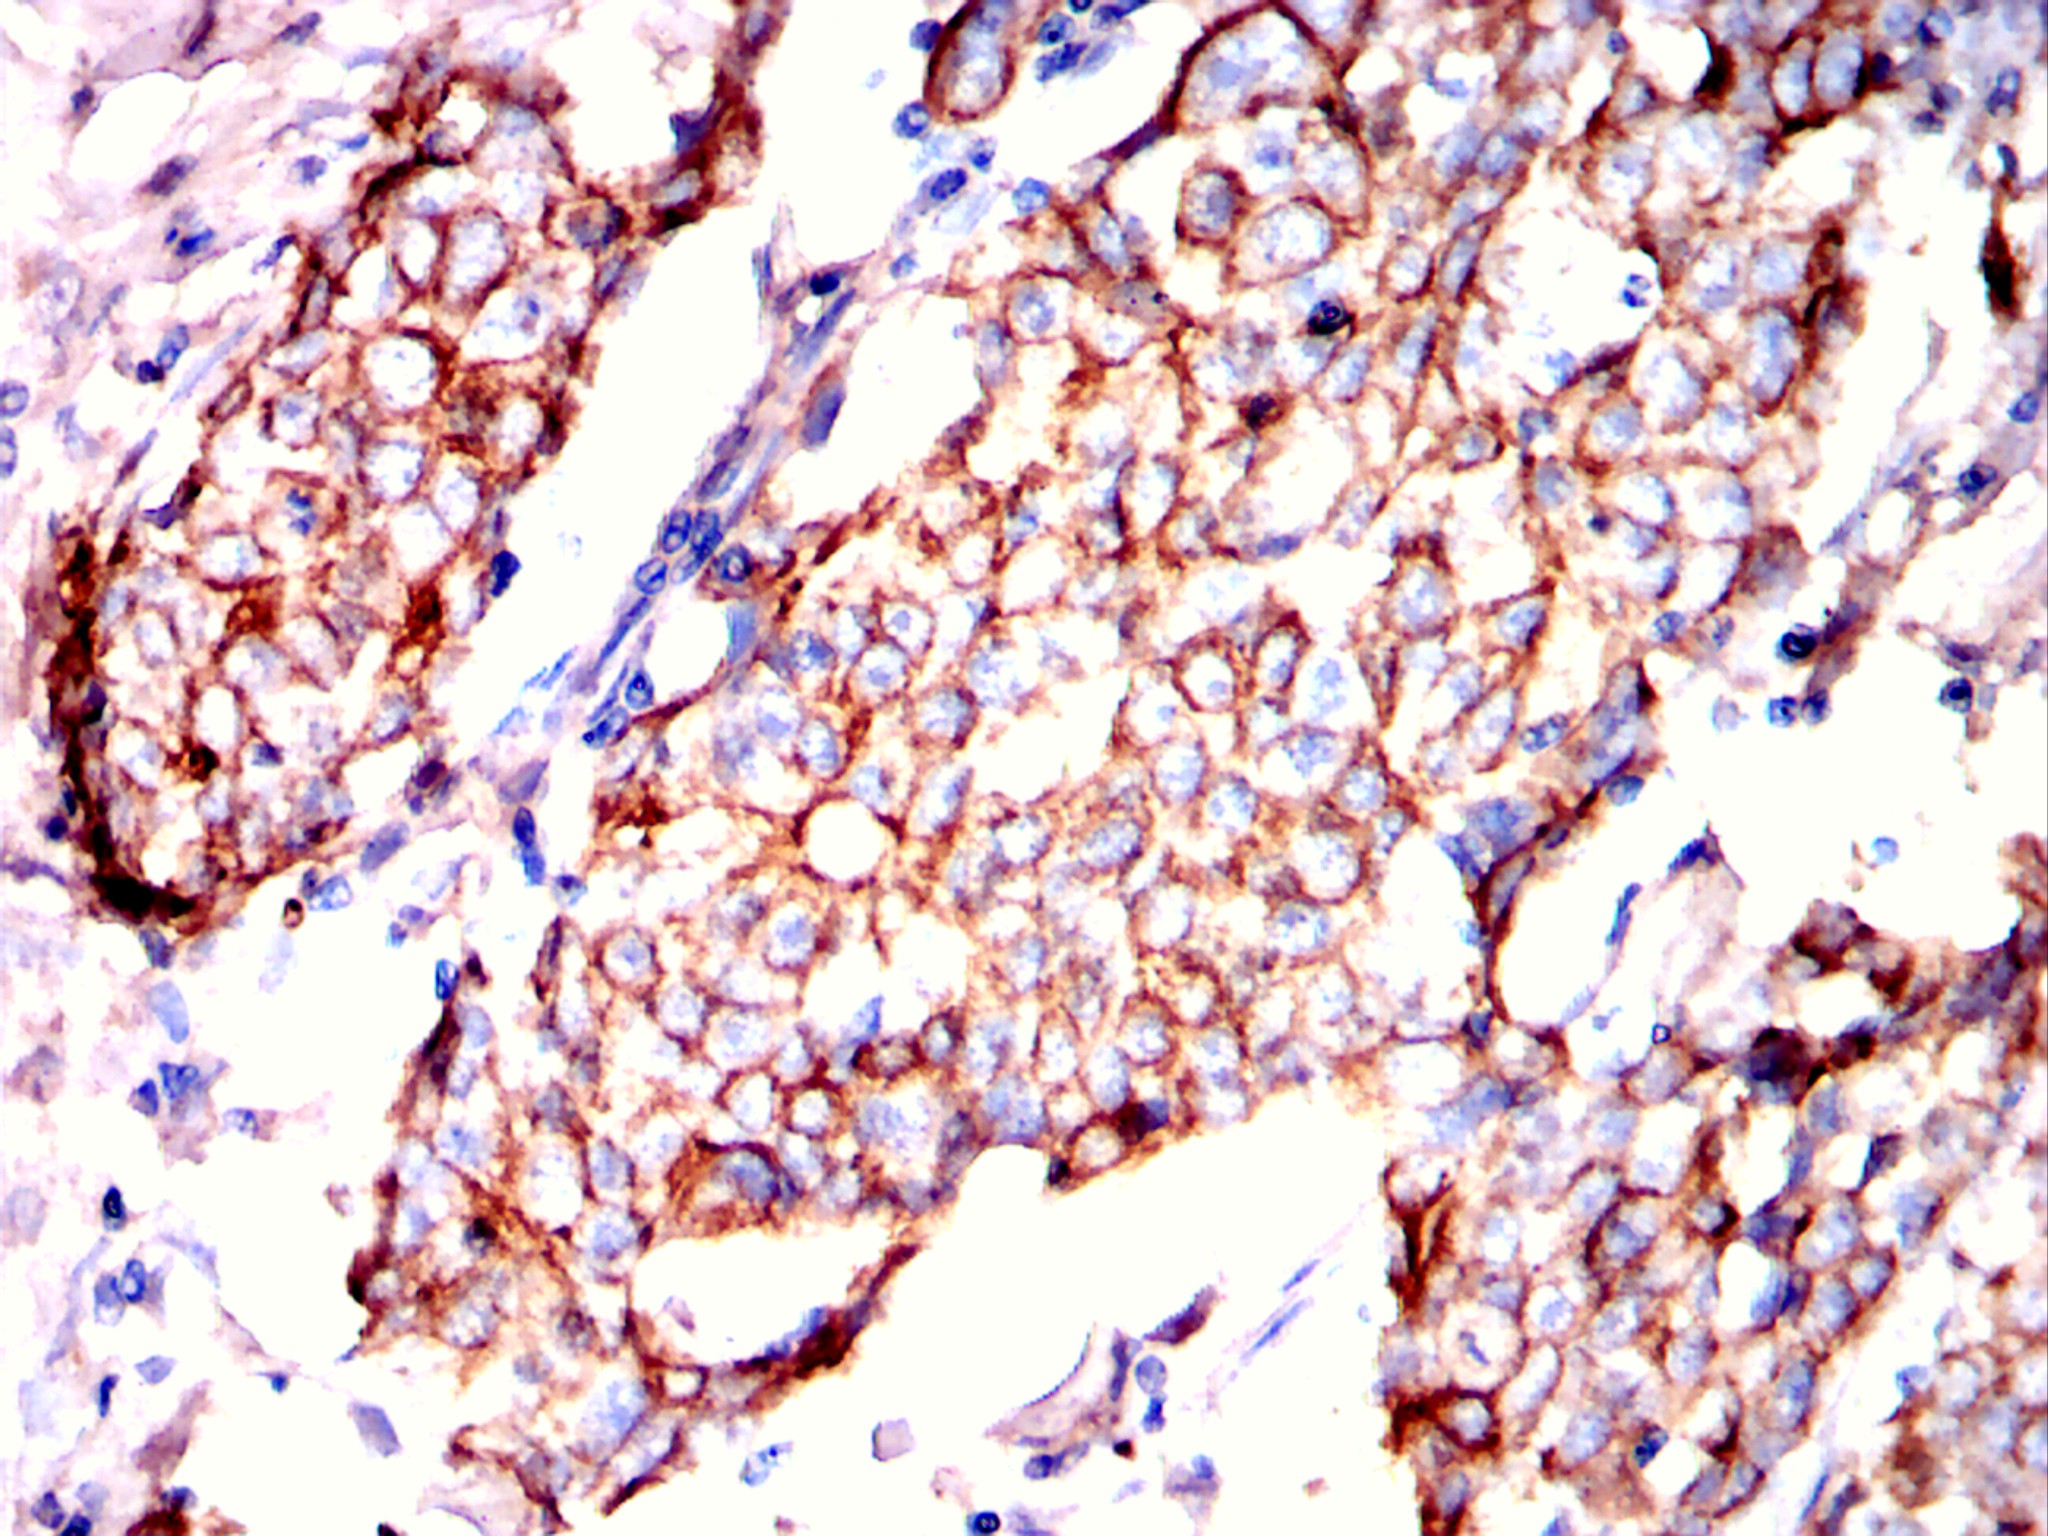

Mouse Monoclonal Antibody to Cytokeratin 19
货号:
20297
别名:
CK19; K1CS; MGC15366; KRT19
应用:
IHC, IF, FCM
反应种属:
Human, Mouse, Rabbit
抗体类型:
Primary antibody
Swissprot:
P08727
规格:
目录价
在线咨询
Description |
|---|
Cytokeratin 19, also known as KRT19, CK19, CK19, K1CS, MGC15366. Entrez Protein NP_002267. It is a member of the keratin family. The keratins are intermediate filament proteins responsible for the structural integrity of epithelial cells and are subdivided into cytokeratins and hair keratins. The type I cytokeratins consist of acidic proteins which are arranged in pairs of heterotypic keratin chains. Unlike its related family members, this smallest known acidic cytokeratin is not paired with a basic cytokeratin in epithelial cells. It is specifically expressed in the periderm, the transiently superficial layer that envelopes the developing epidermis. |
References |
|---|
| 1. Lung Cancer. 2007 Dec;58(3):369-75. 2. Endocr Pract. 2008 Mar;14(2):168-74. |
Specification |
|
|---|---|
| Aliases | CK19; K1CS; MGC15366; KRT19 |
| Entrez GeneID | 3880 |
| Swissprot | P08727 |
| clone | 4F12G9 |
| WB Predicted band size | 44kDa |
| Host/Isotype | Mouse IgG1 |
| Antibody Type | Primary antibody |
| Storage | Store at 4°C short term. Aliquot and store at -20°C long term. Avoid freeze/thaw cycles. |
| Species Reactivity | Human, Mouse, Rabbit |
| Immunogen | Purified recombinant fragment of Cytokeratin 19 (aa80-400) expressed in E. Coli strain. |
| Formulation | Ascitic fluid containing 0.03% sodium azide. |
Application |
|
|---|---|
| IHC | 1/200 - 1/1000 |
| IF | 1/50 - 1/200 |
| FCM | 1/200 - 1/400 |
| ELISA | 1/10000 |
Product Image
-
Flow cytometric analysis of Jurkat cells using KRT19 mouse mAb (green) and negative control (red).

-
Flow cytometric analysis of NIH3T3 cells using KRT19 mouse mAb (green) and negative control (red).

-
Immunohistochemical analysis of paraffin-embedded cervical cancer tissues using KRT19 mouse mAb with DAB staining.

-
Immunohistochemical analysis of paraffin-embedded colon cancer tissues using KRT19 mouse mAb with DAB staining.

-
Immunohistochemical analysis of paraffin-embedded prostate cancer tissues using KRT19 mouse mAb with DAB staining.
-
Immunohistochemical analysis of paraffin-embedded breast cancer tissues using KRT19 mouse mAb with DAB staining.
-
Immunohistochemical analysis of paraffin-embedded rabbit bladder tissues using KRT19 mouse mAb with DAB staining.

-
Immunohistochemical analysis of paraffin-embedded rabbit kidney tissues using KRT19 mouse mAb with DAB staining.

-
Immunohistochemical analysis of paraffin-embedded rabbit small intestine tissues using KRT19 mouse mAb with DAB staining.

-
Immunohistochemical analysis of paraffin-embedded rabbit colon tissues using KRT19 mouse mAb with DAB staining.











鄂公网安备42018502007531号

